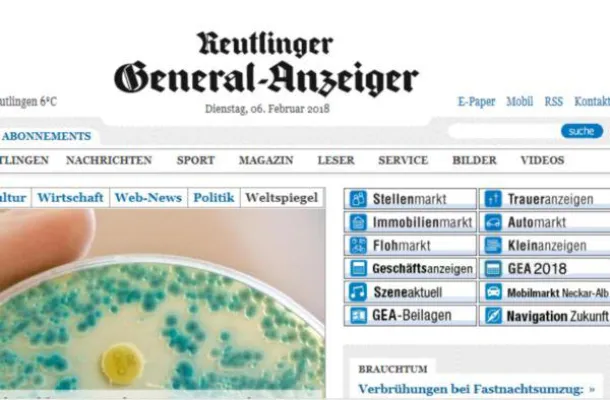
Bild: Barrierefreiheit bei Tageszeitungen–Ein Informatiker mit Handicap analysiert Tageszeitungen im Raum Reutlingen

(openPR) SpitConsult präsentiert App für Android Smartphones zum Messen der radioaktiven Strahlung
Konstanz, Deutschland, 26. September 2011 – Smartphones mit Android Betriebssystem können jetzt benutzt werden, um die radioaktive Strahlung der Umgebung zu messen. SpitConsults App “Radioaktivitäts-Anzeiger” nutzt das Rauschen, das durch die radioaktive Strahlung im Kamera-Chip des Smartphone induziert wird, um die Radioaktivität zu bestimmen.
SpitConsult entwickelte diese App angesichts der Katastrophe von Fukushima, um Menschen ein günstiges Hilfsmittel zum Abschätzen der Umgebungsradioaktivität in die Hand zu geben. “Viele Menschen wollen wissen, ob sie durch radioaktive Strahlung kontaminiert sind oder sein könnten, aber nicht alle können einen Geigerzähler kaufen,” sagte Hans-Joachim Schorn, Gründer von SpitConsult. “Laßt uns eine brauchbare Alternative entwickeln.”
Die App nutzt die Tatsache, daß der Kamera-Chip eines Smartphones durch verschiedene Arten von Rauschen beeinflußt wird, z.B. durch thermisches oder elektrostatisches Rauschen etc. Die radioaktive Strahlung (hauptsächlich Gamma-Strahlung und zu einem gewissen Maß auch Beta-Strahlung) ändert das interne Verhältnis und den Betrag dieses Rauschens. “Radioaktivitäts-Anzeiger” gelingt es, diese Änderungen im Kamera-Bild zu analysieren und daraus die Strahlung zu berechnen, die diese Änderungen verursacht hat.
Da sich die Kamera-Chips in ihrer Empfindlichkeit unterscheiden, muß “Radioaktivitäts-Anzeiger” für jedes Smartphone einmal kalibriert werden. Danach sollte die Meßgenauigkeit ausreichen, um z.B. die Intensität der radioaktiven Strahlung auf dem Erdboden und in einem Flugzeug in 10000 Meter Höhe zu unterscheiden.
Mehr Informationen auf http://www.sos-app.info. "Radioaktivitäts-Anzeiger" läuft auf Smartphones mit Android Betriebssystem Version 2.1 oder höher und ist auf dem Android Market https://market.android.com für EUR 3,56 erhältlich.